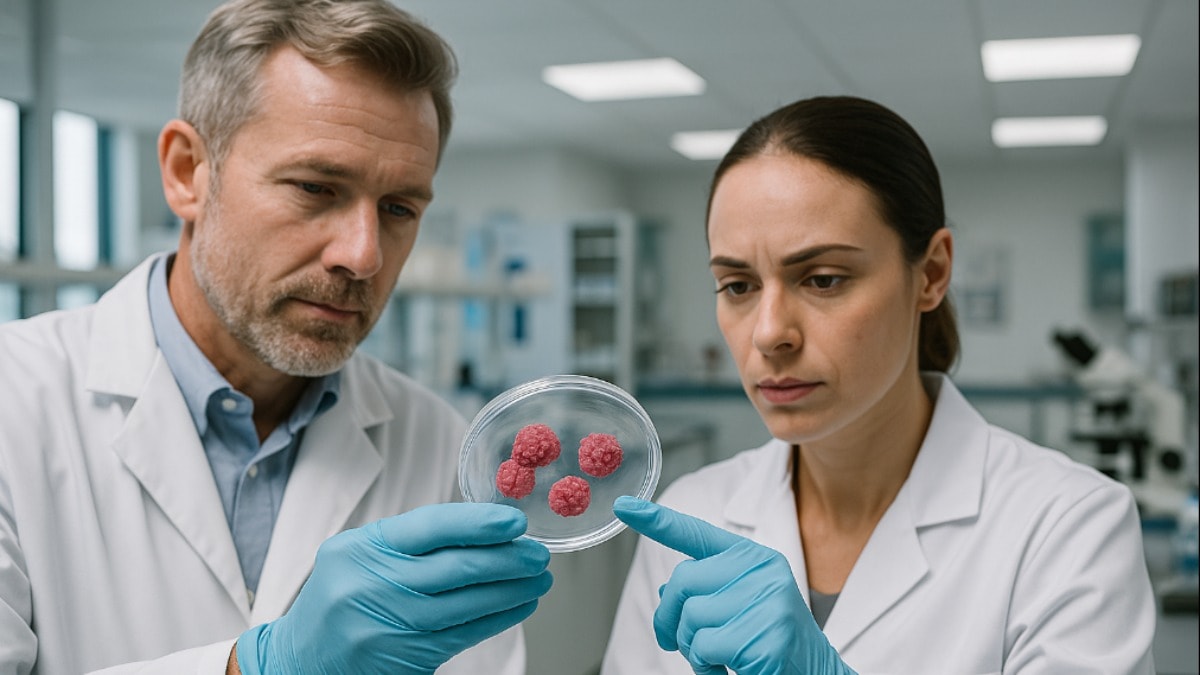

Uluslararası bir bilim ekibi, diyabet tedavisinde çığır açabilecek bir başarıya imza atarak insan insülin üreten pankreas hücre kümelerini ilk kez 3D yazıcıyla üretmeyi başardı. Bilim insanlarına göre bu gelişme, kişiselleştirilmiş ve vücuda yerleştirilebilen diyabet tedavilerine bir adım daha yaklaşıldığını gösteriyor.
Gerçek insan hücreleri kullanılarak geliştirilen ve cilt altına yerleştirilmek üzere tasarlanan dayanıklı ve yoğun adacık yapıları, laboratuvar ortamında üç hafta boyunca canlı ve işlevsel kalmayı başardı. Bu süreçte glikoza karşı güçlü bir insülin tepkisi gösteren adacıklar, umut verici sonuçlar sundu.
Wake Forest Üniversitesi Rejeneratif Tıp Enstitüsü'nden Dr. Quentin Perrier liderliğindeki ekip, bu çalışmayı Londra’da düzenlenen Avrupa Organ Nakli Derneği Kongresi 2025’te sundu. Perrier, “Bu çalışma, biyoyazıcıyla gerçek insan pankreas adacıklarını kullanan ilk örneklerden biri ve sonuçlar son derece umut verici” diyerek bu gelişmenin bir gün insülin enjeksiyonlarına ihtiyaç duymadan diyabet tedavisine ulaşma hayalini güçlendirdiğini belirtti.
Tip 1 diyabet hastalarında bağışıklık sistemi pankreas adacıklarını yok ediyor ve geleneksel adacık nakli en ağır hastalarda başvurulan bir yöntem olarak biliniyor. Ancak bu süreçte pankreas hücrelerinin çevresindeki doğal destek dokusu olan ekstrasellüler matris (ECM) zarar görüyor ve hücrelerin uzun ömürlü olmasını engelliyor.
Bu sorunu çözmek isteyen ekip, ECM’yi taklit eden özel bir biyomürekkep geliştirdi. Kahverengi alglerden elde edilen alginat ve pankreas ECM’sinden oluşan bu biyomürekkep içinde insan adacıkları askıya alınarak, düşük basınçta ve yavaş hızda bir 3D biyoyazıcıyla dikkatlice yazdırıldı. Bu yöntemle elde edilen gözenekli yapılar, hücrelere oksijen ve besin akışını artırırken damar oluşumunu da destekliyor.
Araştırmada hücrelerin yüzde 90’ından fazlasının canlı kaldığı ve adacıkların doğal şekillerini koruduğu belirtildi. Üç haftalık süreç sonunda glikoza karşı gösterilen insülin tepkisi, geleneksel yöntemle izole edilen adacıklara kıyasla daha güçlü oldu.
Ekip, yöntemi şimdi hayvanlar üzerinde test ediyor ve dondurarak uzun süreli saklama (kriyoprezervasyon) gibi stratejiler üzerinde çalışıyor. Bu sayede tedavinin geniş kitlelere ulaştırılması hedefleniyor.